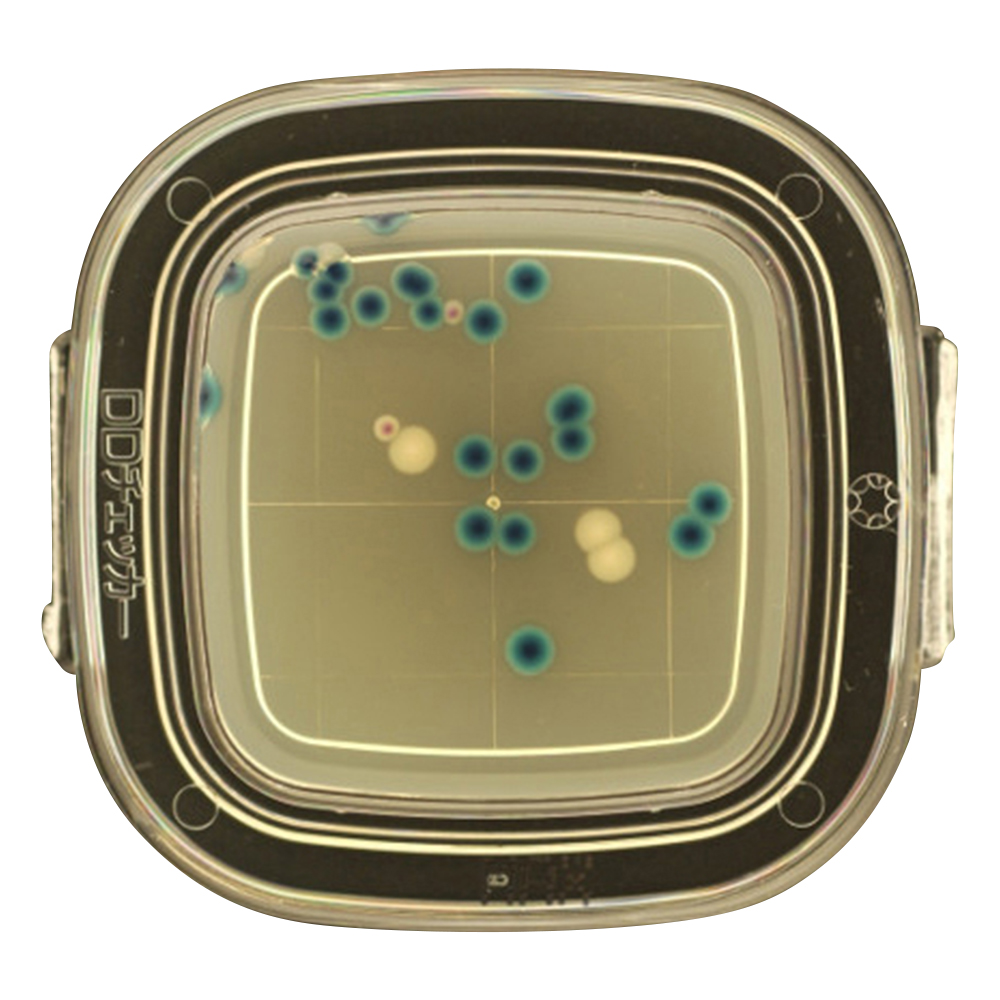
DDチェッカー（細菌検出用培地） MAX寒天培地 大腸菌・大腸菌群同時検出用 1箱（100枚入） 04231

|
商品番号
|
商品名・規格・入数 |
通常価格 |
販売価格
|
注文数 |
|

4-3481-19
製品番号:ESB-01H
|
-
 冷蔵
冷蔵
Comilu for histamine ヒスタミンセンサー用検体希釈液 ESB-01H
11本
(11本あたり1,200円(税込10% 1,320円))
|
- メーカー希望小売価格
-
1,200円
(税込 1,320円)
|
-
-
1,200 円
(税込 1,320 円)
|
ご注文にはログインが必要です
|
|

4-3481-13
製品番号:EE-01H
|
-
 取寄せ
取寄せ
Comilu for histamine ヒスタミンセンサー用検体抽出器セット 1箱(25本入) EE-01H
11箱(25本入り)
(11箱(25本入り)あたり19,000円(税込10% 20,900円))
|
- メーカー希望小売価格
-
19,000円
(税込 20,900円)
|
-
-
19,000 円
(税込 20,900 円)
|
ご注文にはログインが必要です
|
|

4-3481-14
製品番号:EEL-01H
|
Comilu for histamine ヒスタミンセンサー用検体抽出器(大)セット 1パック(10本入) EEL-01H
11パック(10本入り)
(11パック(10本入り)あたり9,950円(税込10% 10,945円))
|
- メーカー希望小売価格
-
9,950円
(税込 10,945円)
|
-
-
9,950 円
(税込 10,945 円)
|
ご注文にはログインが必要です
|
|

4-3481-17
製品番号:EP-01H
|
-
 取寄せ
取寄せ
Comilu for histamine ヒスタミンセンサー用検体抽出器(大)圧搾器 EP-01H
11個
(11個あたり4,500円(税込10% 4,950円))
|
- メーカー希望小売価格
-
4,500円
(税込 4,950円)
|
-
-
4,500 円
(税込 4,950 円)
|
ご注文にはログインが必要です
|
|

4-3481-11
製品番号:EC-01H_10
|
-
 取寄せ
取寄せ
-
 冷蔵
冷蔵
Comilu for histamine ヒスタミンセンサー用酵素センサチップ 10枚入 EC-01H_10
11パック(10枚入り)
(11パック(10枚入り)あたり20,000円(税込10% 22,000円))
|
- メーカー希望小売価格
-
20,000円
(税込 22,000円)
|
-
-
20,000 円
(税込 22,000 円)
|
ご注文にはログインが必要です
|
|

4-3481-12
製品番号:EC-01H_01
|
-
 取寄せ
取寄せ
-
 冷蔵
冷蔵
Comilu for histamine ヒスタミンセンサー用酵素センサチップ EC-01H_01
11パック
(11パックあたり2,500円(税込10% 2,750円))
|
- メーカー希望小売価格
-
2,500円
(税込 2,750円)
|
-
-
2,500 円
(税込 2,750 円)
|
ご注文にはログインが必要です
|
|

4-3481-16
製品番号:ECA-01H
|
-
 取寄せ
取寄せ
Comilu for histamine ヒスタミンセンサー用酵素センサーチップアダプター ECA-01H
11個
(11個あたり1,000円(税込10% 1,100円))
|
- メーカー希望小売価格
-
1,000円
(税込 1,100円)
|
-
-
1,000 円
(税込 1,100 円)
|
ご注文にはログインが必要です
|
|

4-3481-15
製品番号:ESC-01H
|
-
 取寄せ
取寄せ
-
 冷蔵
冷蔵
Comilu for histamine ヒスタミンセンサー用酵素センサーチップ洗浄液 1パック(2本入) ESC-01H
11パック(2本入り)
(11パック(2本入り)あたり800円(税込10% 880円))
|
- メーカー希望小売価格
-
800円
(税込 880円)
|
-
-
800 円
(税込 880 円)
|
ご注文にはログインが必要です
|
|

4-1250-01
製品番号:4201
|
-
 取寄せ
取寄せ
-
 冷蔵
冷蔵
DDチェッカー(細菌検出用培地) DD寒天培地 一般細菌検出用 1箱(100枚入) 04201
11箱(100枚入り)
(11箱(100枚入り)あたり14,550円(税込10% 16,005円))
|
- メーカー希望小売価格
-
15,000円
(税込 16,500円)
|
-
-
14,550 円
(税込 16,005 円)
|
ご注文にはログインが必要です
|
|
4-1250-08
製品番号:4231
|
-
 取寄せ
取寄せ
-
 冷蔵
冷蔵
DDチェッカー(細菌検出用培地) MAX寒天培地 大腸菌・大腸菌群同時検出用 1箱(100枚入) 04231
11箱(100枚入り)
(11箱(100枚入り)あたり14,550円(税込10% 16,005円))
|
- メーカー希望小売価格
-
15,000円
(税込 16,500円)
|
-
-
14,550 円
(税込 16,005 円)
|
ご注文にはログインが必要です
|
|

4-1250-05
製品番号:4271
|
-
 取寄せ
取寄せ
-
 冷蔵
冷蔵
DDチェッカー(細菌検出用培地) MLCB寒天培地 サルモネラ検出用 1箱(100枚入) 04271
11箱(100枚入り)
(11箱(100枚入り)あたり14,550円(税込10% 16,005円))
|
- メーカー希望小売価格
-
15,000円
(税込 16,500円)
|
-
-
14,550 円
(税込 16,005 円)
|
ご注文にはログインが必要です
|
|

4-1250-03
製品番号:4241
|
-
 取寄せ
取寄せ
-
 冷蔵
冷蔵
DDチェッカー(細菌検出用培地) MSEY寒天培地 黄色ブドウ球菌検出用 1箱(100枚入) 04241
11箱(100枚入り)
(11箱(100枚入り)あたり14,550円(税込10% 16,005円))
|
- メーカー希望小売価格
-
15,000円
(税込 16,500円)
|
-
-
14,550 円
(税込 16,005 円)
|
ご注文にはログインが必要です
|
|

4-1250-04
製品番号:4261
|
-
 取寄せ
取寄せ
-
 冷蔵
冷蔵
DDチェッカー(細菌検出用培地) TCBS寒天培地 腸炎ビブリオ検出用 1箱(100枚入) 04261
11箱(100枚入り)
(11箱(100枚入り)あたり14,550円(税込10% 16,005円))
|
- メーカー希望小売価格
-
15,000円
(税込 16,500円)
|
-
-
14,550 円
(税込 16,005 円)
|
ご注文にはログインが必要です
|
|

4-1250-07
製品番号:4251
|
-
 取寄せ
取寄せ
-
 冷蔵
冷蔵
DDチェッカー(細菌検出用培地) TGSE寒天培地 黄色ブドウ球菌検出用 1箱(100枚入) 04251
11箱(100枚入り)
(11箱(100枚入り)あたり14,550円(税込10% 16,005円))
|
- メーカー希望小売価格
-
15,000円
(税込 16,500円)
|
-
-
14,550 円
(税込 16,005 円)
|
ご注文にはログインが必要です
|
|

4-1250-06
製品番号:4221
|
-
 取寄せ
取寄せ
-
 冷蔵
冷蔵
DDチェッカー(細菌検出用培地) X-GAL寒天培地 大腸菌群検出用 1箱(100枚入) 04221
11箱(100枚入り)
(11箱(100枚入り)あたり14,550円(税込10% 16,005円))
|
- メーカー希望小売価格
-
15,000円
(税込 16,500円)
|
-
-
14,550 円
(税込 16,005 円)
|
ご注文にはログインが必要です
|
|

4-1250-02
製品番号:4211
|
-
 取寄せ
取寄せ
-
 冷蔵
冷蔵
DDチェッカー(細菌検出用培地) デオキシコレート寒天培地 大腸菌群検出用 1箱(100枚入) 04211
11箱(100枚入り)
(11箱(100枚入り)あたり14,550円(税込10% 16,005円))
|
- メーカー希望小売価格
-
15,000円
(税込 16,500円)
|
-
-
14,550 円
(税込 16,005 円)
|
ご注文にはログインが必要です
|
|

63-2993-49
製品番号:63191
|
-
 取寄せ
取寄せ
DDテスターII 1台 63191
11個
(11個あたり28,400円(税込10% 31,240円))
|
- メーカー希望小売価格
-
28,400円
(税込 31,240円)
|
-
-
28,400 円
(税込 31,240 円)
|
ご注文にはログインが必要です
|
|

65-9404-74
製品番号:5040
|
-
 取寄せ
取寄せ
DHL寒天培地(顆粒)300g入 05040
11個(300g入り)
(11個(300g入り)あたり5,600円(税込10% 6,160円))
|
- メーカー希望小売価格
-
5,600円
(税込 6,160円)
|
-
-
5,600 円
(税込 6,160 円)
|
ご注文にはログインが必要です
|
|

64-8070-24
製品番号:PA039
|
-
 取寄せ
取寄せ
DTcubeスタンド PA039
11個
(11個あたり15,000円(税込10% 16,500円))
|
- メーカー希望小売価格
-
15,000円
(税込 16,500円)
|
-
-
15,000 円
(税込 16,500 円)
|
ご注文にはログインが必要です
|
|

4-5420-55
製品番号:61977
|
-
 冷蔵
冷蔵
Easy Plate 真菌(カビ・酵母)数測定用(25枚/袋×4袋/箱×5箱) YM-R 61977
11ケース(4袋×5箱入り)
(11ケース(4袋×5箱入り)あたり67,900円(税込10% 74,690円))
|
- メーカー希望小売価格
-
70,000円
(税込 77,000円)
|
-
-
67,900 円
(税込 74,690 円)
|
ご注文にはログインが必要です
|